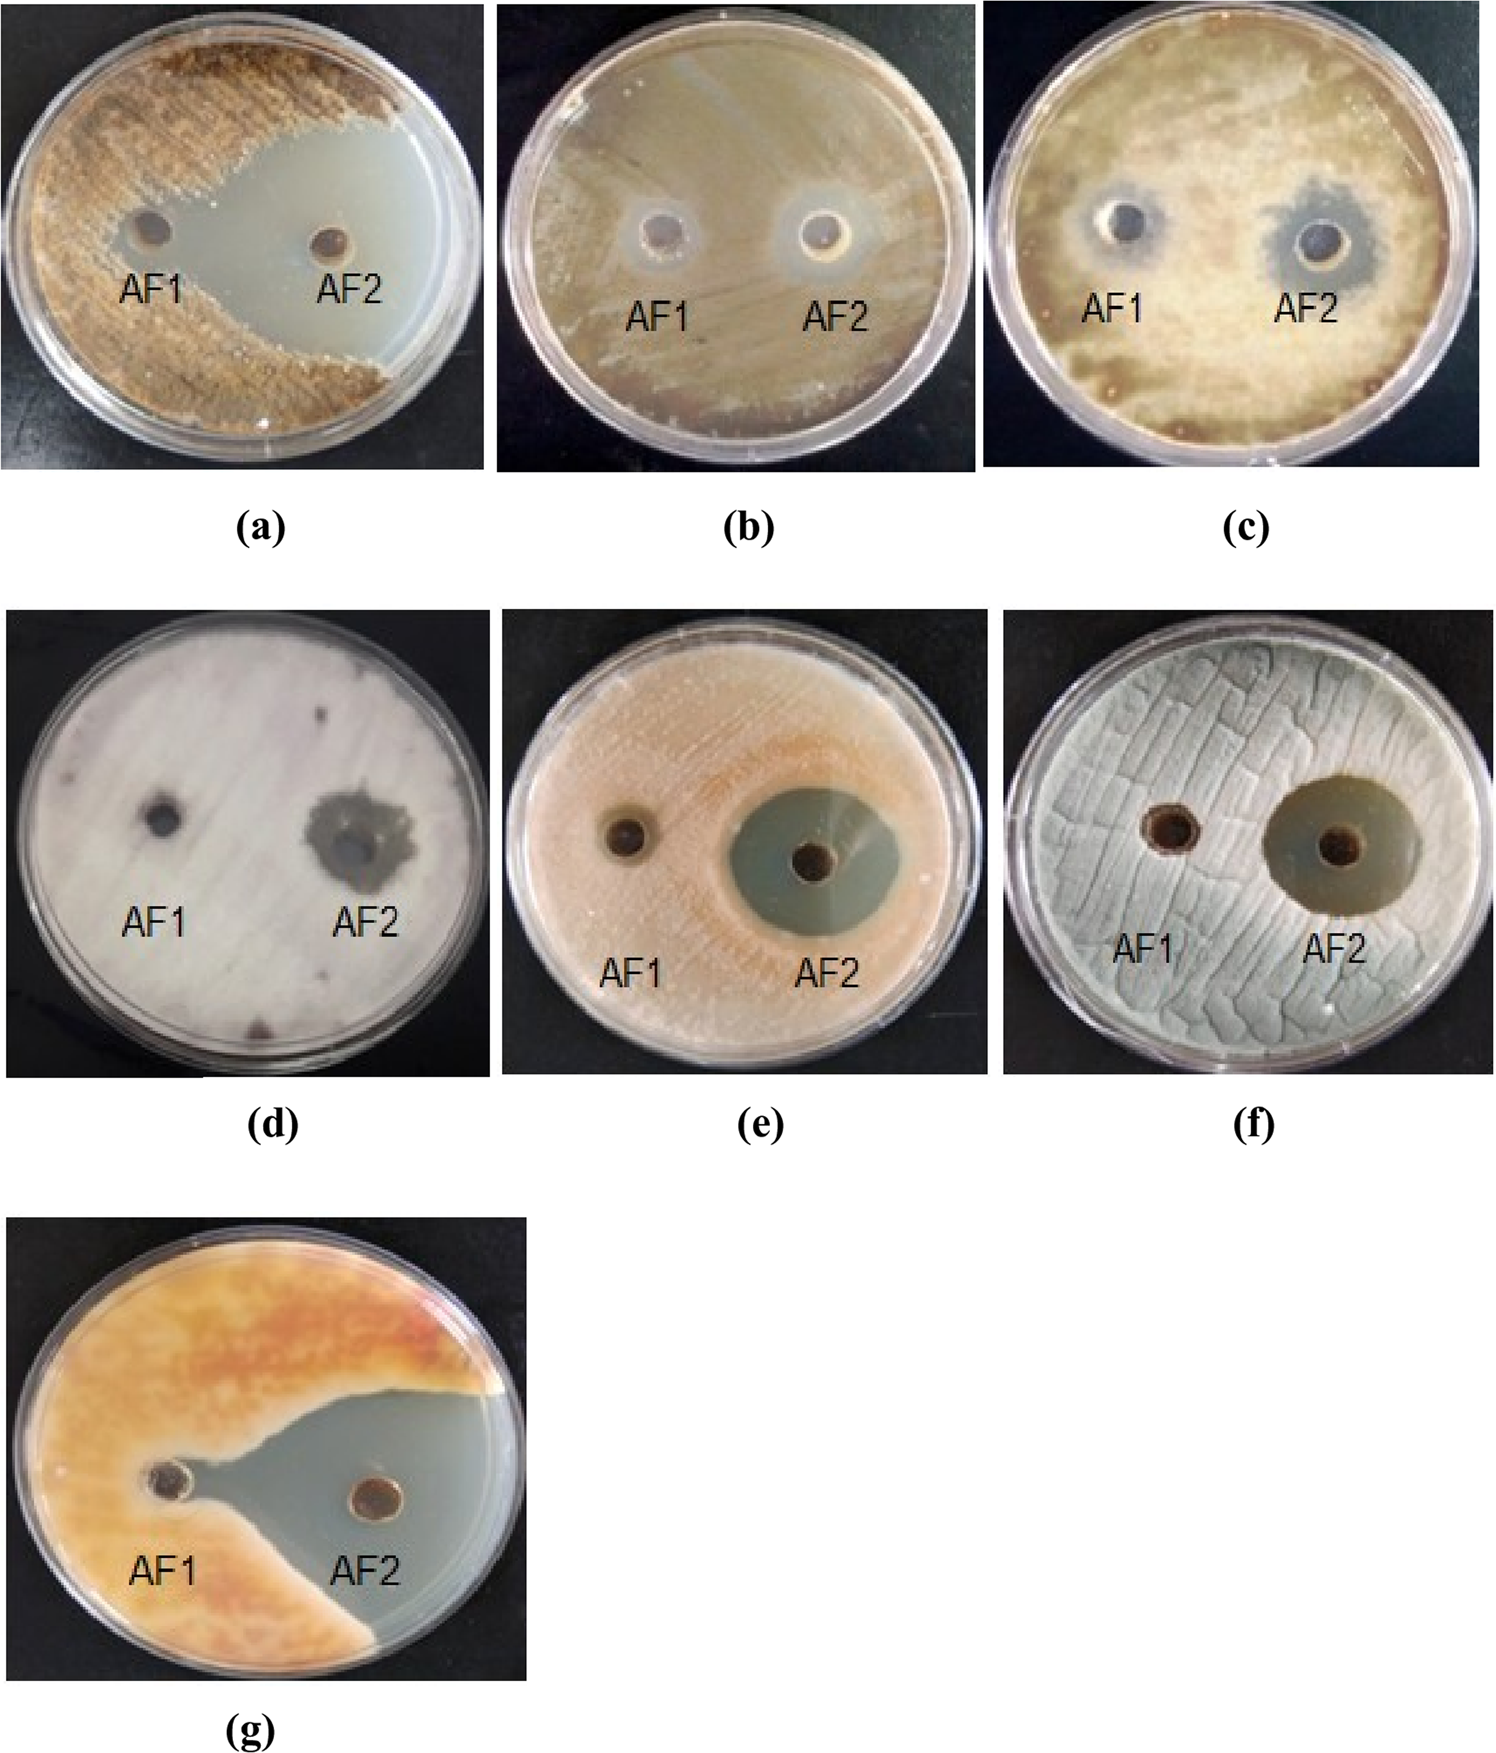
Figure 7

Figure 7
Zones of inhibition exhibited by active fractions AF1 and AF2 of A. destruens AKL-3 against different phytopathogenic fungi (a) A. brassicicola (b) A. alternata (c) A. mali (d) C. beticola (e) F. oxysporum (f) C. herbarum (g) C. gloeosporioides.
